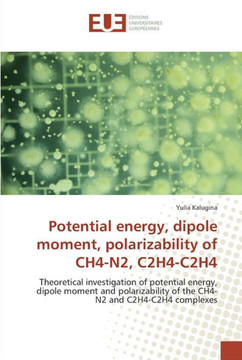
Potential energy, dipole moment, polarizability of ch4-n2, c2h4-c2h4

World Scientific Publishing Company
Lepton Dipole Moments (V20)
Product Code:
9789814271837
ISBN13:
9789814271837
Condition:
New
$295.28

Lepton Dipole Moments (V20)
$295.28
This book provides a self-contained description of the measurements of the magnetic dipole moments of the electron and muon, along with a discussion of the measurements of the fine structure constant, and the theory associated with magnetic and electric dipole moments. Also included are the searches for a permanent electric dipole moment of the electron, muon, neutron and atomic nuclei. The related topic of the transition moment for lepton flavor violating processes, such as neutrinoless muon or tauon decays, and the search for such processes are included as well. The papers, written by many of the leading authors in this field, cover both the experimental and theoretical aspects of these topics.
| Author: B. Lee Roberts |
| Publisher: World Scientific Publishing Company |
| Publication Date: 40328 |
| Number of Pages: 772 pages |
| Binding: Science |
| ISBN-10: 9814271837 |
| ISBN-13: 9789814271837 |